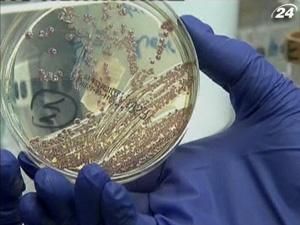
Кишечную палочку обнаружили в водопроводе Копенгагена Кишечную палочку обнаружили в водопроводе Копенгагена

Вероятно, бактерия, которая недавно убила в Европе несколько десятков человек, попала в воды во время сильных дождей, которые не прекращались в столице Дании. Жителей Копенгагена обязывают кипятить воду из водопровода перед употреблением. Если копенгагенцы не прислушаются к советам экспертов, они могут на собственном организме почувствовать, что собой представляет пресловутая E.coli.
Пока чтос информации о пострадавших от недуга не поступало. Мутировавший штамм бактерии, напомним, недавно вызвал в Европе вспышку кишечной инфекции, в результате которой погибли около полусотни человек.